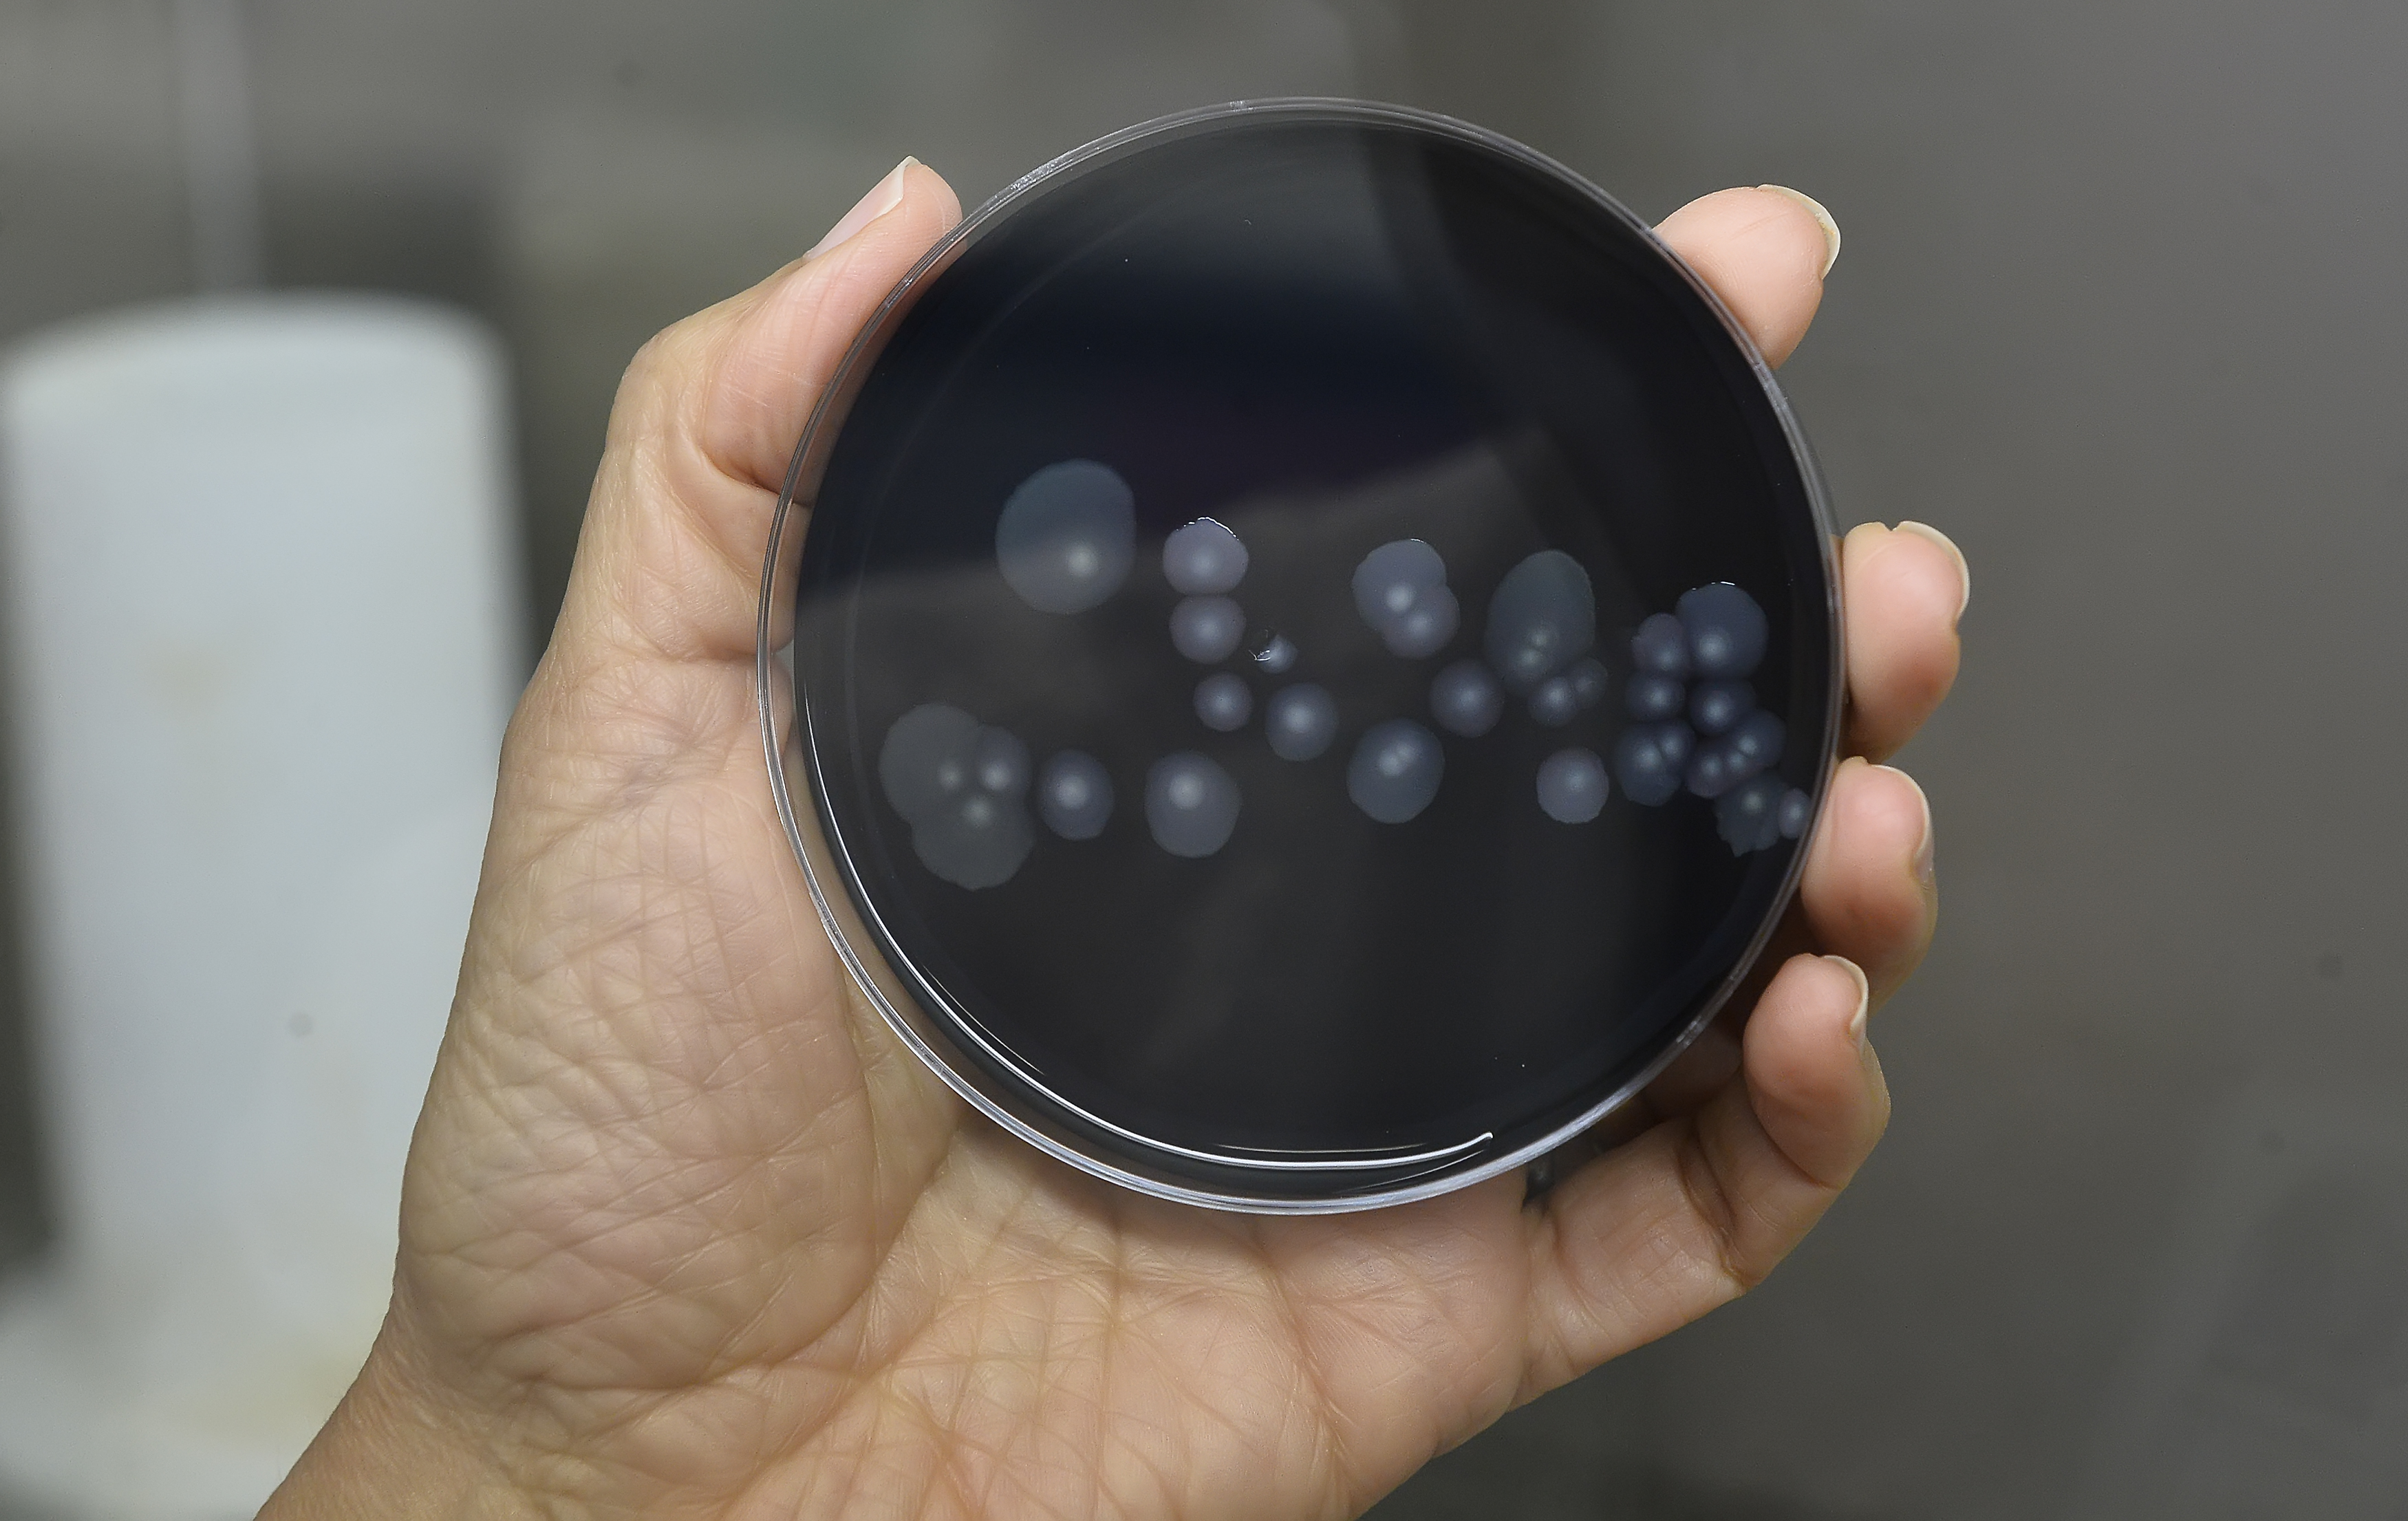

Se la chiusura a oltranza di uffici ed esercizi commerciali è stata, ed è tuttora, la prima arma di difesa contro il coronavirus, il prolungato lockdown degli edifici potrebbe contribuire alla diffusione di un’altra affezione polmonare: la malattia dei legionari, ovvero la legionellosi.
Di cosa si tratta
La legionella fu scoperta dopo un focolaio scoppiato nel 1976 durante una convention dell’American Legion in un hotel di Filadelfia: dei 221 contagiati, 34 morirono. Le persone colpite soffrivano di un tipo di polmonite che alla fine divenne nota come malattia dei legionari. La legionella è un tipo di batterio che si trova naturalmente in ambienti di acqua dolce, come laghi e corsi d’acqua. Può diventare un problema quando prolifera e si diffonde in sistemi idrici per l’edilizia creati dall’uomo come rubinetti per lavandini, torri di raffreddamento industriali, vasconi, fontane decorative e giochi d’acqua, serbatoi e grandi impianti idraulici. Quando la legionella cresce e si moltiplica in un sistema idrico, la legionellosi viene normalmente acquisita per via respiratoria mediante inalazione, aspirazione o microaspirazione di aerosol contenente il batterio. Il tasso di mortalità correlato all’infezione da legionella dipende da alcuni fattori specifici ma, complessivamente, si aggira tra il 5% e il 10%. Se diagnosticata precocemente, la malattia dei legionari rappresenta un rischio per la salute molto inferiore rispetto al Covid-19: la maggior parte dei casi può essere curata con successo con antibiotici e l’infezione non si propaga da uomo ad uomo.
Il pericolo dopo il lockdown
Esperti di sanità pubblica, soprattutto negli Usa, stanno esortando i proprietari di impianti, attività e fabbriche di tutto il mondo a riaprire accuratamente gli edifici per prevenire la proliferazione della legionella. La chiusura improvvisa e a oltranza di scuole, fabbriche, aziende e uffici ha creato anche una brusca interruzione del trattamento delle acque e dei sistemi idrici: la mancanza di acqua clorata che fluisce attraverso i tubi, combinata con sbalzi di temperatura irregolari, crea condizioni ideali per i batteri che causano la malattia. Inoltre, il batterio prolifera preferibilmente in un intervallo di temperature fra i 20 e 42 °C, facilmente raggiungibili in luoghi chiusi ma soprattutto con l’arrivo della stagione calda (almeno nel nostro emisfero).
Al momento, numerosi paesi nel Mondo stanno per optare per una riapertura e, dunque, qualsiasi struttura commerciale lasciata chiusa o sottoutilizzata per più di tre settimane è a rischio focolaio, a meno che le tubature dell’acqua non siano adeguatamente lavate e igienizzate. Quelle maggiormente a rischio includono scuole, palestre, fabbriche, hotel, ristoranti e centri chirurgici ambulatoriali. Secondo la guida aggiornata mercoledì dai Centri statunitensi per il controllo e la prevenzione delle malattie (CDC), la minaccia si applica anche a vasche idromassaggio, fontane d’acqua, sistemi di irrigazione e milioni di torri di raffreddamento negli edifici commerciali.
Se è plausibile pensare che la maggior parte delle grandi società dotate di consulenti sanitari siano consapevoli del problema dei sistemi idrici stagnanti, questa sarà una sfida per negozi di piccole dimensioni, centri benessere e hotel ma anche per chi dovesse riaprire abitazioni private con impianti idrici complessi abbandonate all’improvviso.
L’allarme dagli Usa
La legionellosi è fra le principali malattie causate dal cattivo trattamento delle acque e dei sistemi idrici soprattutto negli Stati Uniti. È per questo che oltreoceano l’allarme torna a farsi sentire in previsione delle riaperture previste. Quasi 50.000 persone sono state infettate tra il 2000 e il 2015, secondo il CDC: dopo la polmonite le persone sane di solito si riprendono, ma spesso necessitano di ricovero in ospedale e antibiotici per curare l’infezione polmonare. Circa uno su 10 muore, secondo il CDC, ma tra coloro che contraggono il morbo durante una degenza in ospedale, uno su quattro non sopravvive. Durante l’estate del 2015, New York ebbe uno dei più grandi e mortali focolai della malattia dei legionari nella storia degli Stati Uniti. Un totale di 138 casi e 16 morti vennero collegati ad un’unica torre di raffreddamento nel South Bronx. Da allora, la città oggi martoriata dal Covid-19, iniziò a regolare la manutenzione delle torri di raffreddamento, sospettate n.1 nello scoppio del focolare. Lo stesso anno, 12 morti a Flint, nel Michigan, furono collegati a un focolaio di malattia del legionario, dopo che i funzionari comunali trasferirono la fonte d’acqua della città da un lago a un fiume senza prendere le dovute precauzioni: l’episodio era legato ai bassi livelli di cloro nel sistema idrico comunale, poi confermato dagli scienziati, in occasione della più ampia crisi idrica che la città dovette affrontare.
Il rischio immediato della riapertura, negli Usa come nel resto del mondo, è legato non solo al timore di una congestione eccessiva del sistema sanitario, già così provato, ma la minaccia della legionella è aggravata dal fatto che i pazienti tendono a mostrare gli stessi sintomi dei pazienti con coronavirus, tra cui tosse, brividi e febbre, rendendo possibile una diagnosi errata. Dai primi studi effettuati dopo il caso di Wuhan, un recente paper di studiosi cinesi pubblicato su The Lancet ha evidenziato che una buona parte dei pazienti affetti da coronavirus aveva contratto anche la malattia dei legionari, rendendo spesso difficile comprendere quale sia stata la causa scatenante di alcuni decessi. Casi, riscontrati anche in Giappone che, pur se fatali, hanno non solo riportato in auge il problema legionella, ma hanno evidenziato l’importanza della diagnosi differenziale durante l’attuale epidemia di Covid-19.
Abbonati e diventa uno di noi
Se l'articolo che hai appena letto ti è piaciuto, domandati: se non l'avessi letto qui, avrei potuto leggerlo altrove? Se pensi che valga la pena di incoraggiarci e sostenerci, fallo ora.